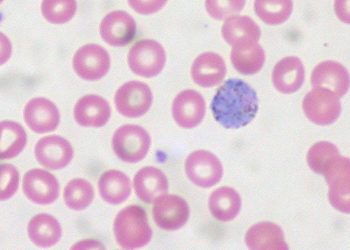
RTS,SA/S01 anti-malarial vaccine efficacy wanes significantly over time

Originally published by Harvard Health.
What Is It?
Malaria is an infection caused by single-celled parasites that enter the blood through the bite of an Anopheles mosquito. These parasites, called plasmodia, belong to at least five species. Most human infections are caused by either Plasmodium falciparum or Plasmodium vivax.
Plasmodium parasites spend several parts of their life cycle inside humans and another part inside mosquitoes. During the human part of their life cycle, Plasmodium parasites infect and multiply inside liver cells and red blood cells.
Some infected blood cells burst because of the multiplying parasites inside. Many more infected red blood cells are broken down by your spleen or liver, which filter out and remove damaged or aging red blood cells from circulation. Both Plasmodium parasites in the bloodstream and irritants that are released from broken red blood cells cause malaria symptoms.
Most deaths from malaria are caused by P. falciparum, which causes severe disease. Before P. falciparum malaria causes a red blood cell to burst, it can make the surface of the cell stick to other cells like it. This causes the blood to clot within small blood vessels, which can severely damage organs.
People who have lived all their life in a country with a high rate of malaria have typically been exposed to malaria parasites many times. After the first exposure, your immune system begins to protect you, so re-infection may cause few or no symptoms.
Your immune system does not remain active against malaria for more than a few years if you are not exposed again. This explains why people can live for years in the tropics without being bothered by malaria. However, people from the tropics who spend several years in another country may lose their immune protection.
People who have never had a malaria infection (such as young children and travelers) and pregnant women are more likely to have severe symptoms from malaria.
Usually, symptoms appear within the first several weeks after the infected mosquito bites you. In people with P. vivax or P. ovale infections, it is possible for some Plasmodium parasites to remain inside the liver. If this happens, dormant parasite forms can become active and trigger malaria symptoms months or years after the first exposure.
In regions where there is a high rate of malaria infection, malaria can be spread in other ways than through a mosquito bite, such as through contaminated blood transfusions, transplantation of contaminated organs and shared drug needles. In pregnant women, malaria infection can pass through the bloodstream to the developing fetus, causing low birth weight or fetal death. This is most common with P. falciparum infection.
Malaria is one of the major causes of preventable death in the world today. It affects more than 500 million people worldwide and causes 1 to 2 million deaths every year. It is a tropical disease. Therefore, it is rare in the United States and European countries, where almost all cases are seen in people who have traveled from countries where malaria is common.
In the tropics, the particular species of Plasmodium varies from country to country. In some areas, new strains of malaria have emerged that are resistant to some antimalarial drugs. This emergence of drug-resistant strains has complicated the treatment and prevention of malaria in tropical countries and in travelers.
Symptoms
Symptoms of malaria can begin as early as six to eight days after a bite by an infected mosquito. They include:
- High fever (up to 105 degrees Fahrenheit) with shaking chills
- Profuse sweating when the fever suddenly drops
- Fatigue
- Headache
- Muscle aches
- Abdominal discomfort
- Nausea, vomiting
- Feeling faint when you stand up or sit up quickly
If treatment is delayed, more severe complications of malaria can occur. Most people who develop these complications are infected with the P. falciparum species. They include:
- Brain tissue injury, which can cause extreme sleepiness, delirium, unconsciousness, convulsions and coma
- Pulmonary edema, which is a dangerous accumulation of fluid inside the lungs that interferes with breathing
- Kidney failure
- Severe anemia, resulting from the destruction of infected red blood cells and decrease in the production of new red blood cells
- Yellow discoloration of the skin
- Low blood sugar
Diagnosis
Your doctor may suspect that you have malaria based on your symptoms and your history of foreign travel. When your doctor examines you, he or she may find an enlarged spleen because the spleen commonly swells during a malaria infection.
To confirm the diagnosis of malaria, your doctor will take samples of blood to be smeared on glass slides. These blood smears will be stained with special chemicals in a laboratory and examined for Plasmodium parasites. Blood tests will be done to determine whether malaria has affected your levels of red blood cells and platelets, the ability of your blood to clot, your blood chemistry, and your liver and kidney function.
Expected Duration
With proper treatment, symptoms of malaria usually go away quickly, with a cure within two weeks. Without proper treatment, malaria episodes (fever, chills, sweating) can return periodically over a period of years. After repeated exposure, patients will become partially immune and develop milder disease.
Prevention
Researchers are working to create a vaccine against malaria. Vaccination is expected to become an important tool to prevent malaria in the future.
One way to prevent malaria is to avoid mosquito bites with the following strategies:
- As much as possible, stay indoors in well-screened areas, especially at night when mosquitoes are most active.
- Use mosquito nets and bed nets. It’s best to treat the nets with the insect repellant permethrin.
- Wear clothing that covers most of your body.
- Use an insect repellent that contains DEET or picaridin. These repellents are applied directly to your skin, except around your mouth and eyes. If you choose a picaridin-based repellant, you will need to reapply it every several hours.
- Apply permethrin to clothing.
It is strongly recommended that you take preventive medication when you travel to a region of the world that has malaria. Keep in mind that these medications can prevent most malaria infections, but travelers occasionally get malaria even when they are taking one of these drugs. If you develop an illness with fever within a year of your return, seek immediate medical attention and tell a health care professional about your travel.
The four antimalarial medications most commonly prescribed in the United States for foreign travel include:
- Chloroquine (Aralen)—This is the most commonly prescribed antimalarial medication in countries where there are no drug-resistant strains of malaria. This medication is taken once a week, from one to two weeks prior to your departure until four weeks after you return. This regimen is well tolerated by most people, with a few patients experiencing nausea, itching, dizziness, blurry vision and headache. You can minimize these symptoms by taking the drug after meals.
- Mefloquine (Lariam)—This is the treatment of choice for travel to most regions of sub-Saharan Africa and other areas with high levels of chloroquine-resistant malaria parasites. Like chloroquine, the medication is taken once a week, from one to two weeks before departure until four weeks after your return. Common side effects include bad dreams, concentration difficulties, nausea and dizziness. Hallucinations and seizures can occur, but they are rare. Depression is another uncommon side effect. You may be advised against taking this medicine if you have an abnormal result from an electrocardiogram or a rhythm disturbance in your heart. You should not take this medication if you have seizures or if you have neurological or psychiatric disease.
- Doxycycline (Vibramycin)—This medication commonly is usually prescribed for travelers who aren’t able to take chloroquine or mefloquine. Doxycycline should be taken once per day, from two days before departure to four weeks after you return. It’s important to protect yourself diligently from sun exposure while you are taking doxycycline because it can cause you to be more sensitive to the sun, increasing your risk of sunburn. Pregnant women and young children should not take this drug.
- Atovaquone and proguanil (Malarone)—This drug commonly is prescribed for the prevention of chloroquine-resistant malaria. You need to take one tablet at about the same time each day, starting one to two days before departure until seven days after your return. The most common side effects of Malarone include abdominal pain, nausea, vomiting and headache. You should not take this medication if you are pregnant or breastfeeding or you have severe kidney disease.
In addition to one of these medications, you also may need to take a medication called primaquine (sold as a generic) when you return home if you stayed for more than several months in an area of the world where you had heavy exposure to mosquitoes. This extra precaution eliminates dormant forms of malaria that may have entered your liver and survived even though you were taking preventive medication during your trip.
Primaquine is taken daily for two weeks after you have left the area where malaria is common. People with a genetic shortage of a normal enzyme (G6PD deficiency) cannot take primaquine because they can develop severe anemia.
There are potential drug interactions between some of the medications used to treat human immunodeficiency virus (HIV) and those used to treat malaria. If you are HIV-positive, you should check with your doctor before taking malarial medications.
Treatment
Malaria is treated with antimalarial drugs and measures to control symptoms, including medications to control fever, antiseizure medications when needed, fluids and electrolytes. The type of medications that are used to treat malaria depends on the severity of the disease and the likelihood of chloroquine resistance. The drugs available to treat malaria include:
- Chloroquine
- Quinine
- Hydroxychloroquine (Plaquenil)
- Artemether and lumefantrine (Coartem)
- Hydroxychloroquine (Plaquenil)
- Atovaquone (Mepron)
- Proguanil (sold as a generic)
- Mefloquine
- Clindamycin (Cleocin)
- Doxycycline.
People with falciparum malaria have the most severe symptoms. People with falciparum malaria may need to be monitored in the intensive care unit of a hospital during the first days of treatment because the disease can cause breathing failure, coma and kidney failure.
For pregnant women, chloroquine is the preferred treatment for malaria. Quinine, proguanil and clindamycin typically are used for pregnant people with malaria that is resistant to chloroquine.
When To Call a Professional
See your doctor before you travel to a tropical country where malaria is common, so that you can take medications to prevent malaria. After you return, call your doctor if you develop a high fever within the first several months.
Prognosis
In the United States, most people with malaria have an excellent prognosis if they are treated properly with antimalarial drugs. Without treatment, malaria can be fatal, particularly P. falciparum. People with severe malaria have the greatest danger of death. From 10% to 40% of people with severe malaria die even with advanced medical treatment. P. falciparum is more likely to cause severe disease among young children, pregnant women and travelers who are exposed to malaria for the first time.
Additional Info
Centers for Disease Control and Prevention (CDC)
1600 Clifton Road
Atlanta, GA 30333
Phone: 404-639-3534
Toll-Free: 1-800-311-3435
http://www.cdc.gov/